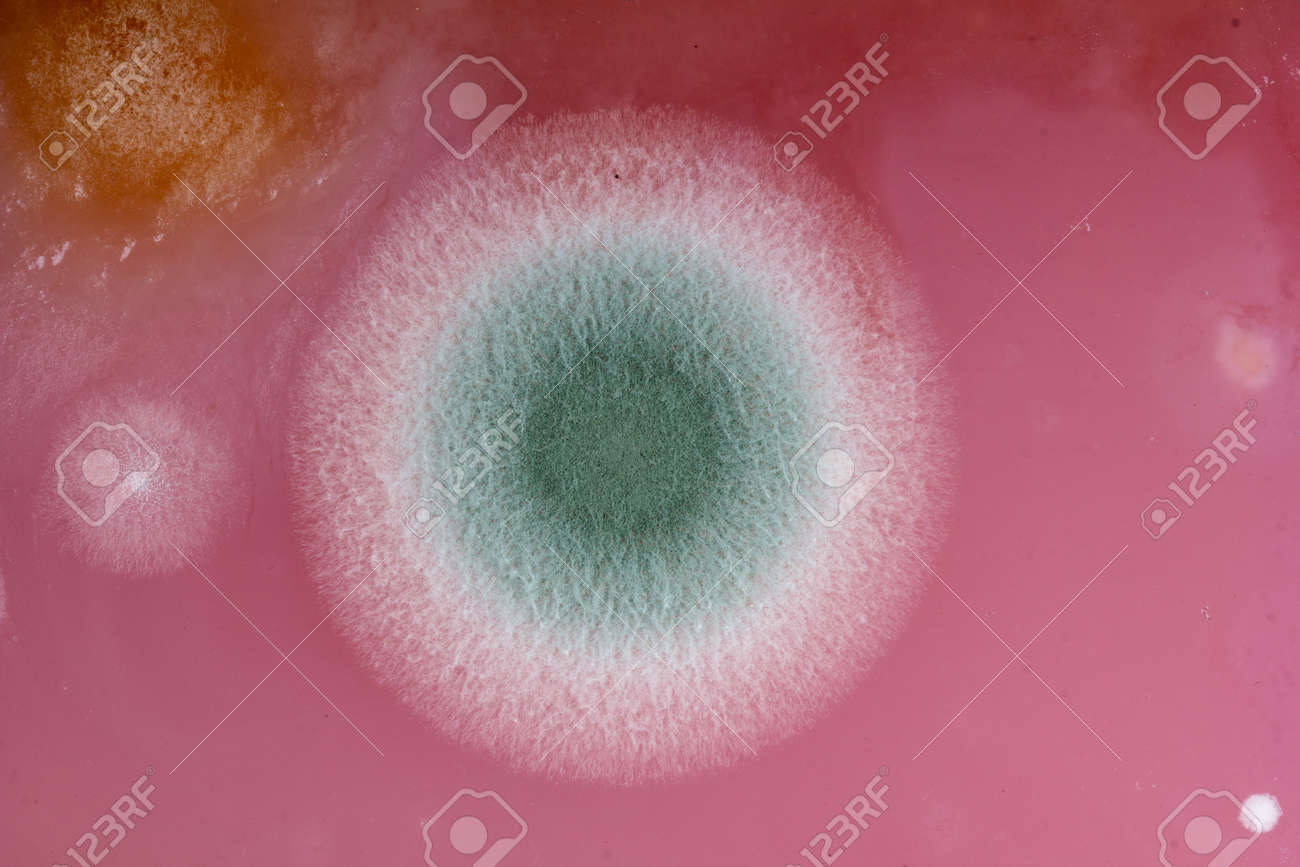
etiam-dictum-ipsum-a-felis

Download
Close
Автор:
id:
Ключевые слова:
abstract, background, cherry, circle, closeup, colony, color, culture, drink, food, fruits, fungi, harmful, jam, jelly, kissel, kitchen, macro, microbiology, mold, mushrooms, nature, object, orange, pattern, photo, pink, poisoning, product, purple, round, science, spots, sweet, syrup, top view,





